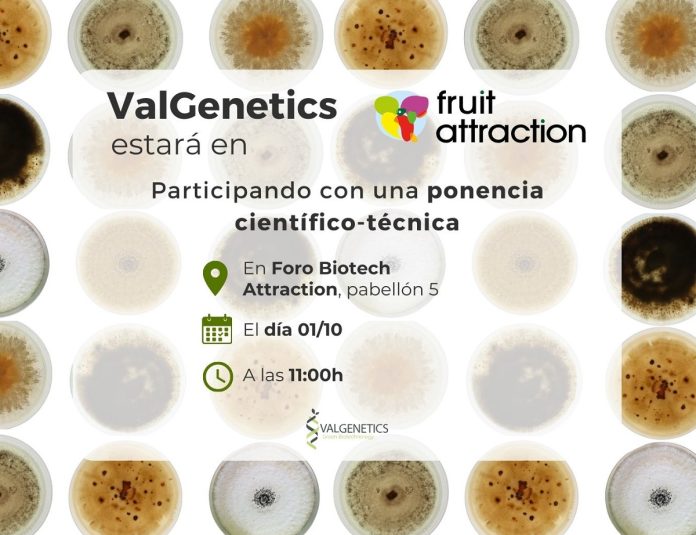

ValGenetics presentará en la próxima edición de Fruit Attraction, que se celebra en IFEMA Madrid del 30 de septiembre al 2 de octubre, su nueva plataforma Ecoefficacy, con la que puede valorar la eficacia y modo de acción de productos bioestimulantes y agentes de biocontrol. Además de participar como expositor, el laboratorio de biotecnología vegetal impartirá una charla científico-técnica en el Foro Biotech Atraction (Pabelló 5), el 1 de octubre, a las 11:00.
Ecoefficacy integra resultados de análisis bioquímicos, biológicos, microbiológicos y moleculares. Es una herramienta que permite comparar productos, visualizar su viabilidad y modo de acción y seleccionar los más adecuados para distintas condiciones ambientales.
La plataforma es capaz de probar productos aplicados en la agricultura en condiciones reales, considerando el suelo, la temperatura, la humedad y el ecosistema. Ofrece información clave para elegir el mejor producto, sustancia o microorganismo desde las primeras etapas de desarrollo. Además, proporciona datos valiosos a los equipos comerciales sobre las ventajas agronómicas y el modo de acción de sus productos.
La información proporcionada por Ecoefficacy cumple una doble función. Por un lado, actúa como respaldo técnico para facilitar que los organismos reguladores aprueben los productos. Por otro, contribuye a que el sector agrario comprenda de manera más clara cómo estos pueden mejorar tanto la calidad como la rentabilidad de sus cultivos, favoreciendo de esta manera a que se genere un entorno positivo y receptivo de aceptación de los productos biológicos de uso agrícola.
Ecoefficacy se basa en la investigación de características agronómicas clave en los productos, la estandarización de análisis para evaluar su viabilidad en campo, el desarrollo de bioensayos que caractericen el modo de acción y la creación de una plataforma que proporcione datos claros y fiables sobre ventajas agronómicas y viabilidad. Este sistema permite a ValGenetics ofrecer un servicio innovador, tanto a fabricantes como a agricultores. Facilita la toma de decisiones, optimiza prácticas agrícolas y potencia el desarrollo de productos sostenibles y competitivos en el mercado.